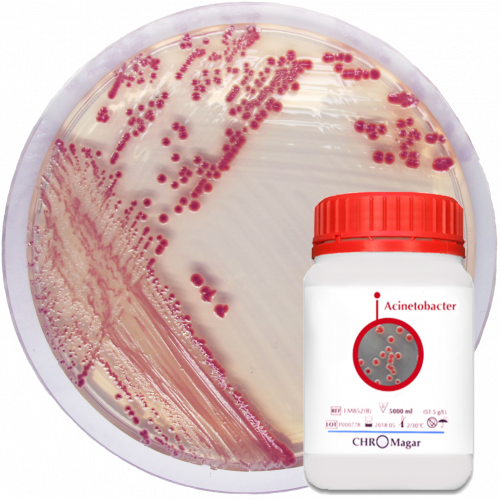
CHROMagar™ Acinetobacter Kit
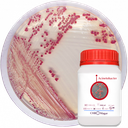
CHROMagar™ Acinetobacter Kit

CHROMagar™ Acinetobacter Kit
Catalog No :
CAS Number :
Brand :
In Stock
For detection of Acinetobacter spp. and MDR Acinetobacter
Specifications:
| Application | Clinical microbiology | ||
| Storage Temperature | Room Temperature | ||
| Product Type | Culture Medium | Forms | Powder |
| Product Brand | CHROMagar™ | Target Organism Class | acinetobacter spp. |
| Product Grade | Microbiology grade | ||
For Detection of Acinetobacter spp. and Multi-Drug Resistant (MDR) Strains
CHROMagar™ Acinetobacter is a selective and differential chromogenic culture medium designed for the detection and presumptive identification of Acinetobacter spp. from clinical, environmental, and screening samples, including multi-drug resistant (MDR) Acinetobacter baumannii. Co lonies of Acinetobacter spp. typically appear distinctive red after overnight aerobic incubation, while most other Gram-negative organisms are blue or inhibited.
This medium helps healthcare facilities perform active surveillance and infection control screening by rapidly identifying colonized patients or contaminated surfaces, aiding in early interventions to prevent hospital-acquired infections.
🔹 Key Features & Benefits
- ✅ Red Colony Coloration: Highly selective detection of Acinetobacter spp., especially A. baumannii, in red colonies, even in complex polymicrobial samples.
- ✅ Unique Medium on the Market: The only chromogenic medium specifically designed for reliable Acinetobacter detection.
- ✅ MDR Acinetobacter Screening: Can be supplemented with MDR-specific agents (optional CR102 and CR103-25) for enhanced detection of carbapenem-resistant or multidrug-resistant strains.
- ✅ Broad Sample Compatibility: Works with rectal, nare, wound swabs, stool, urine, and environmental surface samples.
- ✅ Rapid Results: Readable after 18–24 hours of aerobic incubation at 35–37 °C.
🔹 Intended Use
CHROMagar™ Acinetobacter is intended for:
- Qualitative detection and presumptive identification of Acinetobacter spp., including drug-susceptible and MDR strains
- Use in colonization screening programs for patients at risk of Acinetobacter carriage
- Environmental hygiene monitoring on medical equipment, furniture, or surfaces in healthcare environments
- Early warning for potential outbreaks or transmission events
⚠️ This medium is not intended for direct diagnosis or treatment decisions. Confirmatory testing and full antimicrobial susceptibility profiling should follow.
🔹 Colony Appearance
| Organism | Colony Color |
|---|---|
| Acinetobacter spp. | Red |
| Other Gram-negative organisms | Blue or inhibited |
🔹 Performance & Background
Acinetobacter spp., particularly A. baumannii, have emerged as significant nosocomial pathogens due to their ability to survive in harsh environments, colonize medical devices and patients, and develop resistance to multiple antibiotic classes. Infections caused by MDR strains (resistant to cephalosporins, quinolones, and carbapenems) are difficult to treat and contribute to increased morbidity and mortality, particularly in ICUs.
Routine culture methods often struggle with overgrowth of background flora or lack of selectivity. CHROMagar™ Acinetobacter overcomes these limitations, providing a clear and selective visual readout even in complex sample matrices.
🔹 Supplement Options for MDR Detection
| Supplement | Pack Size | Reference | Description |
|---|---|---|---|
| CR102 | 5000 mL supplement | CR102 | Enhances selectivity for MDR strains |
| CR103-25 | 25 L supplement | CR103-25 | Bulk pack for high-throughput labs |
🔹 Test Procedure
- Sample Types: Rectal, nasal, wound swabs; urine; stool; environmental surface swabs
- Inoculation: Direct plating or after enrichment if necessary
-
Incubation:
- Temperature: 35–37 °C
- Time: 18–24 hours under aerobic conditions
-
Interpretation:
- Red colonies indicate presumptive Acinetobacter spp.
- Blue or no growth indicates other Gram-negatives or inhibition
🔹 Ordering Information
| Product | Reference | Components Included |
|---|---|---|
| CHROMagar™ Acinetobacter 5000 mL | AC092 | Base AC092(B) + Supplement AC092(S) |
| Optional MDR Supplement 5000 mL | CR102 | MDR supplement for AC092 |
| Optional MDR Supplement 25 L | CR103-25 | MDR supplement (bulk format) |
🔹 Storage & Shelf Life
- Storage: 2–8 °C (refrigerated, sealed, dry)
- Shelf Life: Up to 24 months from manufacture when stored properly
CHROMagar™ Acinetobacter is the first and only chromogenic culture medium specifically optimized for selective and differential detection of Acinetobacter spp. and MDR strains. Its distinctive red colony appearance enables fast, accurate screening of patients and environments for colonization, making it an essential tool for infection control teams, clinical microbiology labs, and AMR surveillance programs.
- Pack Size: 5000 mL Pack (Base medium + Supplement) 5000 mL Pack (Base medium + AC092(S) & MDR Supplement)




 0
0